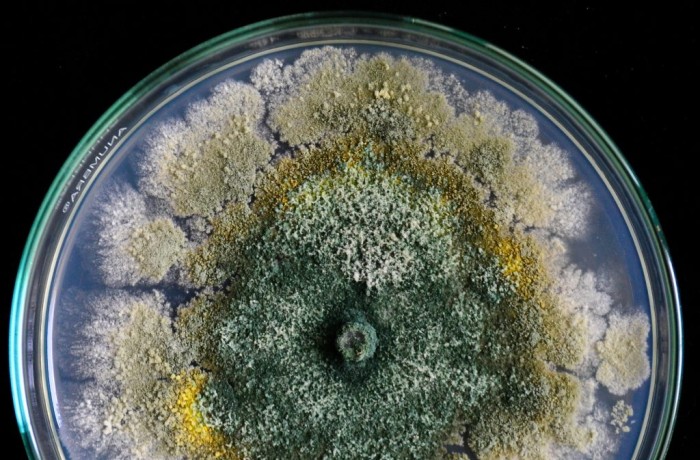

Indice
Negli ultimi anni, la crescente consapevolezza degli impatti ambientali derivanti dall’uso intensivo di agrofarmaci e fertilizzanti chimici ha spinto il settore agricolo a cercare soluzioni più sostenibili ed efficienti. In questo scenario, il biocontrollo sta emergendo come approccio cardine per ridurre la pressione chimica sugli agroecosistemi, contribuendo al contempo al mantenimento di rese e qualità produttiva. Tra le strategie disponibili, particolare attenzione è rivolta ai microrganismi benefici, alcuni dei quali – oltre a migliorare l’efficienza nutrizionale delle piante e la tolleranza agli stress abiotici – esercitano anche effetti di biocontrollo. Ed è proprio questa duplice azione – sul piano della nutrizione e della protezione – a rendere i microrganismi benefici perfettamente allineati con le priorità del Green Deal europeo e della strategia Farm to Fork, che puntano a un’agricoltura più sostenibile, attenta alla biodiversità e meno dipendente dalla chimica.
Questa integrazione tra nutrizione e difesa trova una delle sue espressioni più promettenti nei funghi del genere Trichoderma, oggi al centro dell’attenzione per il loro duplice ruolo di biostimolanti microbici. Si tratta di funghi filamentosi ubiquitari, ampiamente studiati per le loro proprietà multifunzionali: micoparassitismo, produzione di metaboliti antifungini, solubilizzazione di nutrienti, miglioramento della struttura del suolo e induzione di resistenza in pianta. Il loro impiego come biostimolanti microbici rappresenta un’alternativa promettente alla riduzione dell’impiego di agrofarmaci e fertilizzanti chimici, contribuendo alla mitigazione degli effetti degli stress biotici e abiotici. Questi microrganismi, per le loro capacità di interazione con le colture agricole e con gli agenti fitopatogeni, sono classificati come promotori della crescita delle piante (PGPM) e agenti di biocontrollo (BCA). In tale contesto, la ricerca scientifica si sta orientando verso soluzioni a basso impatto ambientale, tra cui la valutazione di biostimolanti microbici in colture agrarie. Il gruppo di ricerca dell’IPSP (Istituto per la Protezione Sostenibile delle Piante), sotto la guida scientifica della Dottoressa Ruocco, ha concluso uno studio scientifico denominato SOS TATA (Sviluppo di nuove tecnologie in agricoltura di precisione per la produzione sostenibile di genotipi di patata con elevate qualità nutrizionali) (finanziato da: H₂0₂0-PON MISE, 2020-2023 e dal Piano Nazionale di Ripresa e Resilienza (PNR), per proposte del Ministero dell’Università e della Ricerca italiano finanziato da l’Unione Europea-NextGenerationEU; Award Number: Ministero dell’Università e della Ricerca, Titolo progetto “ON Foods-Rete di ricerca e innovazione su alimenti e nutrizione Sostenibilità, sicurezza e protezione – Lavorare sugli alimenti). Il Progetto ha previsto la caratterizzazione morfologica e molecolare di ceppi isolati e identificati come T. asperelloides (1A) e T. harzianum (1B) (Figura 1).

L’identificazione è stata confermata da strutture conidiofore ben sviluppate e da sequenze genetiche coerenti con le specie target. I ceppi si sono distinti per la rapida colonizzazione del substrato, l’abbondante sporulazione e la capacità di adattarsi a condizioni ambientali variabili, caratteristiche che li rendono adatti alla formulazione di un prodotto commerciale. Il prodotto formulato, denominato SOSTATA, è stato valutato in relazione a una delle principali colture orticole a livello mondiale: la patata (Solanum tuberosum), seconda solo a cereali come riso e grano in termini di produzione. Grazie all’elevato valore nutritivo, alla versatilità culinaria e adattabilità a diverse condizioni climatiche, la patata rappresenta una risorsa strategica per la sicurezza alimentare. Tuttavia, l’agricoltura intensiva e l’uso massiccio di input chimici hanno esacerbato problemi ambientali quali la degradazione del suolo, la salinizzazione, la perdita di biodiversità microbica e l’aumento della vulnerabilità agli stress abiotici. A ciò si aggiungono fenomeni legati all’instabilità climatica, come siccità prolungate, ondate di calore e piogge irregolari, che compromettono la produttività e impongono l’adozione di pratiche agricole più resilienti.
Saggi in vitro: i Trichoderma fra antagonismo e compatibilità
Le attività in vitro sono state fondamentali per valutare il potenziale dei ceppi selezionati. Nei saggi duali (dual-plate), le due specie di Trichoderma sono state messe a confronto con importanti patogeni: Fusarium oxysporum, Sclerotinia sclerotiorum, Botrytis cinerea e Aspergillus sp. Sono stati allestiti test di antagonismo in vitro per valutare l’attività micoparassitaria di due ceppi di Trichoderma nei confronti di quattro diversi patogeni fungini (Sclerotinia sclerotiorum, Fusarium oxysporum, Aspergillus sp. e Botrytis cinerea). I saggi di biocontrollo sono stati monitorati in base ai diversi requisiti di crescita del patogeno selezionato. La crescita fungina è stata misurata ogni 24 h, fino al giorno in cui si è verificato il contatto tra il micelio del patogeno e quello dell’antagonista. L’esperimento è stato condotto in tre repliche indipendenti. Le colture singole dei patogeni sono state utilizzate come piastre di controllo. Sono stati, inoltre, condotti studi in vitro per saggiare la resistenza dei due isolati di Trichoderma nei confronti di tre fungicidi commerciali.
Il disegno sperimentale: campi, varietà e trattamenti
Le prove in pieno campo sono state effettuare nel biennio 2022–2023 in cinque località italiane: Airola, Cervinara, Maddaloni, Acerra (Campania) e Avezzano (Abruzzo). Sono state seminate quattro varietà di patata con differente ciclo di maturazione: Agata, Colomba, Inova e Cicero. Il disegno sperimentale ha confrontato tre tesi:
- Controllo (C): gestione agronomica aziendale tradizionale;
- Formulato commerciale (O): biostimolante commerciale a base di Trichoderma spp.;
- SOSTATA (W): nuova bioformulazione sperimentale con ceppi di Trichoderma inoculati su riso.
Durante il ciclo colturale sono stati monitorati numerosi parametri morfofisiologici: peso fresco e secco della pianta, numero e peso dei tuberi, resa produttiva e vigoria vegetativa mediante indici multispettrali (NDVI, GNDVI) rilevati da drone.
Risultati dei test in vitro
L’effetto micoparassitario (figura 2) di T. asperelloides (1A) e T. harzianum (1B) è stato condotto con una tecnica a doppia piastra contro patogeni vegetali importanti per l’agricoltura come Sclerotinia sclerotiorum, Fusarium oxysporum, Aspergillus sp. e Botrytis cinerea. L’effetto di inibizione del patogeno dell’isolato 1A di T. asperelloides variava dal 21% contro Asperigillus sp. a un massimo del 36% quando competeva con F. oxysporum. L’isolato 1B di T. harzianum ha invece mostrato un comportamento micoparassitario più variabile, con percentuali di inibizione che vanno da un minimo dello 0% in competizione con B. cinerea a un massimo del 100% contro Aspergillus sp. Dei tre fungicidi saggiati alle dosi di etichetta, Lidal (Tetraconazolo) si è rivelato il più efficace nell’inibire la crescita dei due ceppi di Trichoderma causando, dopo 7 giorni, il 100% e il 54% di inibizione della crescita rispettivamente di T. asperelloides (1A) e T. harzianum (1B). Talendo (Proquinazid) e Biomic (Tannini) non sono risultati efficaci nell’inibire la crescita dei due ceppi di Trichoderma, registrando una percentuale di inibizione pari allo 0% per entrambi i ceppi.

Risultati agronomici: un incremento netto delle prestazioni
In particolare, per quanto riguarda il peso fresco delle piante (figura 3), il trattamento SOSTATA (W) ha permesso di ottenere un peso medio di 598,2 (±5,07) g/pianta, differenze statisticamente significativa rispetto al controllo aziendale (C) che era di 288,4 (±2,68) g/pianta. Il peso fresco dei tuberi di patata del trattamento SOSTATA (W) (1059,5 ± 6,13) g/pianta) è superiore a quello del Controllo (744,6 ± 10,75 g/pianta) e anche rispetto al trattamento con il bioformulato commerciale (O) (732,8 ± 4,9 g/pianta). Osservando i valori di peso secco delle piante, la differenza tra il trattamento SOSTATA (W) (57,3 ± 0,38 g/pianta) e il Controllo (C) (32,8 ± 0,35 g/pianta) è stata significativa, così come per il numero di patate ottenute, con una media di 14,4 tuberi/pianta e di 10,16 tuberi/pianta rispettivamente per il trattamento SOSTATA (W) e per il Controllo aziendale (C). I dati raccolti in figura 4 relativi alla produzione biennale dei tre campi sperimentali mostrano come il trattamento SOSTATA (W) è stato in grado di aumentare la produzione rispettivamente del 20% e del 36% rispetto al prodotto commerciale (O) e al Controllo (C). Inoltre, gli indici NDVI (0,73) e GNDVI (0,57) hanno confermato una vegetazione più densa e fotosinteticamente attiva nelle parcelle trattate con la bioformulazione sperimentale SOSTATA.

Conclusioni
I risultati ottenuti evidenziano il potenziale della bioformulazione del trattamento con SOSTATA (W) come strumento innovativo per migliorare la resa della patata in modo sostenibile. La significativa risposta produttiva, la compatibilità con altri mezzi tecnici e l’adattabilità ai diversi contesti agroambientali ne suggeriscono un possibile utilizzo su scala commerciale. Il lavoro qui descritto rappresenta un passo importante verso un’agricoltura rigenerativa, in grado di coniugare redditività, tutela ambientale e innovazione.
- Leggi anche: Biocontrol Conference 2025: scopri il programma
A cura di: Angelo Napolitano e Francesca Palomba – Istituto per la sostenibilità e la Protezione della Pianta (IPSP), CNR – Portici (NA)
© fruitjournal.com